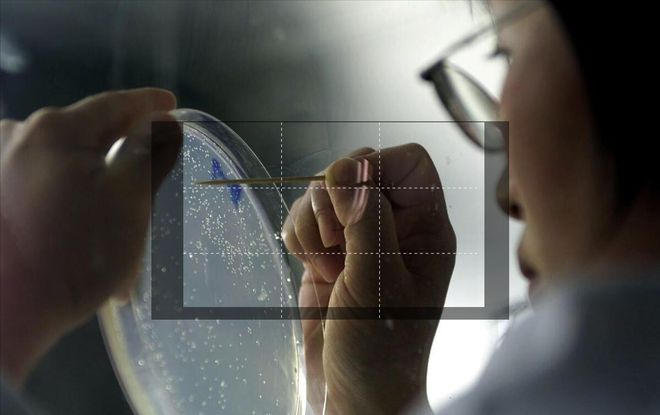
物理科普无从下手？这五个方法助力家长开启孩子科学之旅(图7)

彩神 - 中国原创软件官方平台
物理科普无从下手?这五个方法助力家长开启孩子科学之旅
彩神物理科普宛如一把神奇的钥匙,为孩子们开启了通往充满无限想象的世界之门。当孩子们接触物理知识时,

细心的家长必定会发现,几乎每个孩子都天生具有强烈的好奇心,他们的心中仿佛住着十万个为什么。比如:为什么我们能够看见东西?为什么电有时危险,有时却很 “温顺”?为什么我们能听到声音?
这些皆是科学家们曾经思索过的问题。这些思考不但能够激发孩子们的想象力,还能够培育他们的科学思维与创新能力。
有数据表明,在接受了良好物理科普教育的孩子当中,约 70% 的孩子能够在日常生活里运用物理知识进行小发明、小创造。他们或许会设计出更为高效的节能装置,为解决能源问题贡献自己的一份微薄之力;亦或创造出新型的交通工具,改变人们的出行方式。

这种创新能力不仅能够改变孩子们自身的人生轨迹,还能对社会的发展进程产生积极的影响。孩子们的创新成果可能会推动科技的进步,促进经济的发展,提升人们的生活质量。就如同历史上众多伟大的科学家一样,他们的创新成就改变了整个世界。
而且,拥有创新能力的孩子在未来的职业选择上也将拥有更多的机遇和优势。他们可以成为科学家、工程师、发明家等,为社会的发展作出更大的贡献。

选择适合小学生阅读的物理科普书籍,例如带有彩色插图、以故事形式阐释物理知识的漫画读物。这类书籍能够将抽象的物理概念转化为孩子们易于理解的故事,从而激发他们的阅读兴趣。例如《大闹物理天宫》共六册,分别讲述电、力、光、声、物质、能量,作者是物理学家李淼。该书曾荣获《中华优秀出版物》《中国国家图书馆文津图书奖》。

在书中,作者以人们耳熟能详的神仙妖怪作为角色,将现代物理学科普轻松传播开来。其内容涵盖六大物理知识体系,上百个物理知识点及概念与初中物理课程的考纲高度契合。
众所周知,初中阶段,孩子面临的竞争相当激烈,为此,很多小学阶段的家长都会提前让孩子学习初中知识。但硬学可能会给孩子带来一定的压力,不妨试试这种较为轻松的方式。大部分孩子都是愿意接受的,毕竟有几个孩子能抵挡得住搞笑漫画故事的魅力呢?

科技馆和博物馆是进行物理科普的绝佳场所。这里有各种互动展品,可以让孩子们亲身体验物理现象。比如,在科技馆的力学展区,孩子们可以通过操作各种机械装置,了解力的作用和机械原理。
在参观过程中,家长或老师可以引导孩子们观察展品,提出问题,激发他们的思考。例如,看到一个倾斜的平面和一个小球,可以问孩子们小球为什么会往下滚,进而引出重力的概念。

如今,网络上有很多优质的物理科普视频。这些视频通常以动画、实验演示等形式呈现物理知识,十分生动有趣。
观看视频后,可以和孩子们一起讨论视频中的内容,加深他们对物理知识的理解。例如,看完一个关于浮力的视频,可以让孩子们回忆一下生活中哪些现象与浮力有关。
引导孩子们观察日常生活中的物理现象。比如,为什么天空是蓝色的?为什么冰会浮在水面上?通过对这些问题的思考,孩子们可以逐渐了解光学、浮力等物理知识。
鼓励孩子们动手做一些简单的物理实验。例如,用杯子和纸片做一个大气压力的实验,让孩子们亲身感受物理的神奇。可以在网上搜索一些适合小学生的物理小实验,和孩子们一起动手尝试。

有很多与物理相关的游戏可以让孩子们在玩的过程中学习物理知识。比如,拼图游戏可以帮助孩子们了解物体的形状和结构;搭建积木可以让孩子们体会力学平衡的原理。
还可以和孩子们一起玩一些物理谜语或问答游戏,增加学习的趣味性。例如,“弯弯藤儿架上爬,串串珍珠上边挂。” 让孩子们猜出谜底是葡萄,然后引导他们思考葡萄为什么会挂在藤上,从而引出重力的概念。

总之,给小学生进行物理科普需要采用生动有趣、多样化的方法,让孩子们在轻松愉快的氛围中感受物理的魅力,激发他们对科学的热爱和探索精神。
特别声明:以上内容(如有图片或视频亦包括在内)为自媒体平台“网易号”用户上传并发布,本平台仅提供信息存储服务。
英超豪门悲喜夜:帕尔默4球切尔西4-2 利物浦2-1登顶 曼城1-1连平
英超豪门悲喜夜:帕尔默4球切尔西4-2 利物浦2-1登顶 曼城1-1连平
中国人民银行9月27日同步实施降准降息——货币政策发力支持稳增长强信心
华为Nova13标准版被确认:60MP前置+50MP主摄,配色也已清晰
【农业地理】高考地理常考的六种农作物种植方式、地理高考中的15种特色农业

